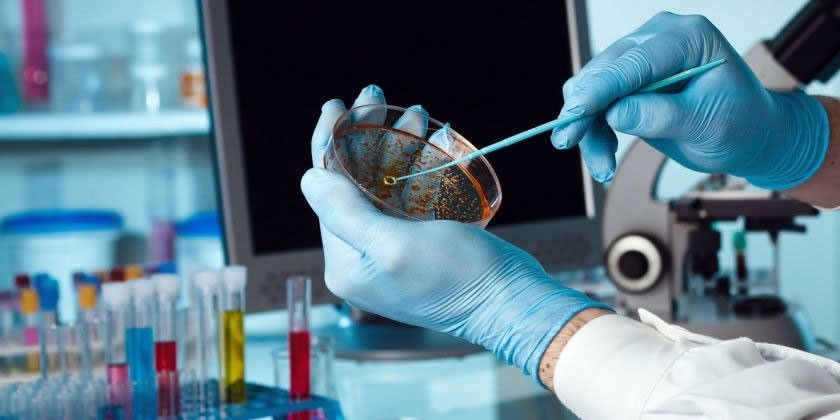
image

Для оценки способности организма сопротивляться инфекционным болезням или для определения фазы патологии применяют анализ крови. Метод ИФА занимает важное место среди лабораторных исследований, он помогает всесторонне изучить деятельность защитной функции крови, определить иммунодефицит при инфекционных заболевания, недугах крови, гормональных, аутоиммунных процессах.
Что такое иммуноферментный анализ крови
Этот метод относится к лабораторным исследованиям, определяет наличие защитных факторов крови белковой природы (антител) к определенным болезнетворным агентам (антигенам). Иммуноферментный анализ крови определяет иммуноглобулины, которые могут обнаруживаться в виде иммунокомплексов. Появляются они при возникновении сложных нейрогуморальных реакций иммунной защиты человека, которые становятся ответом на внедрение чужеродных антигенов.
Против каждого вида болезнетворного агента производятся в организме специфические антитела. Далее происходит связывание патологического микроорганизма или антигена, образуется комплексное соединение «антиген-антитело». Затем оно нейтрализуется, происходит ферментативный лизис, реакция фагоцитоза, и заканчивается процесс выводом из организма. Наличие конкретных комплексов, определяющееся ИФА, говорит о виде возбудителя, вредного вещества у больного.
Мнение врачей:
Иммуноферментный анализ (ИФА) – это высокоточный метод исследования, используемый в медицине для определения наличия антител к различным инфекциям и другим веществам в организме. Результаты ИФА анализа позволяют врачам диагностировать различные заболевания, оценить иммунный статус пациента и назначить соответствующее лечение. Этот метод обладает высокой чувствительностью и специфичностью, что делает его незаменимым инструментом в диагностике инфекционных и аутоиммунных заболеваний. Благодаря ИФА анализу врачи могут оперативно выявлять патологии и контролировать эффективность проводимого лечения, что существенно повышает шансы на выздоровление пациентов.

Классы иммуноглобулинов
Учеными обнаружено и изучено 5 видов иммуноглобулинов: IgE, IgD, IgG, IgM, IgА. Существуют и другие классы, но они находятся еще на стадии исследования, и не до конца выяснена их роль. В практической медицине важное значение имеют А, М, G. Информативность, точность определения базируется на временных промежутках, за которые они появляются, достигают максимума и исчезают.
- Иммуноглобулины IgA (А) – выполняют защитную функцию слизистых мочевыделительной системы, желудочно-кишечного тракта, дыхательных путей. Выявить их при остром начале патологии нельзя, они образуется только через 2 недели после первых признаков болезни, в некоторых ситуациях еще позже. Сосредоточен глобулин А в слизистых тканях (около 80% от общего количества). Оставшаяся часть находится в крови, чтобы обезвреживать и уничтожать микроорганизмы. К 8 неделе после стихания острой фазы патологии количество этих иммуноглобулинов уменьшается до полного исчезновения.
- Первым и главным маркером острого периода развития болезни становятся глобулины IgM (M). Анализ их показывает на 5 сутки после начала появления первых признаков патологии. Выявляет ИФА эти иммуноглобулины первые 6 недель, затем они быстро исчезают.
- Класс иммуноглобулинов IgG (G) показывает остаточный иммунный ответ в крови на патологический процесс.Анализ покажет фактор спустя месяц после начала болезни. Потом они могут еще долгие месяцы, года и даже всю жизнь определяться в анализе. Они защищают человека от рецидива недуга, иногда обеспечивают невозможность вторичного развития патологии. При определении роста иммуноглобулина G подозревают повторное заражение патологией. Для подтверждения проводят несколько проб ИФА с промежутком в 2 недели.
- В паразитологии и аллергологии используется иммуноглобулин IgE (E).
- Иммуноглобулин IgD (D) находится на В-лимфоцитах, небольшая концентрация встречается и у здоровых людей. Достигает максимальных значений после 10 лет жизни человека. При анализе ИФА отмечается рост иммуноглобулина D у пациентов с системными патологиями соединительной ткани, во время беременности, при бронхиальной астме, недугах, которые спровоцированы иммунодефицитным состоянием.

- Анализ на тестостерон у мужчин – как подготовиться и сдавать, показатели нормы и причины отклонений
- Грибковые инфекции у женщин – возбудители, проявления, препараты для терапии и профилактики
- Анализ на тестостерон у женщин – когда назначают и как сдавать, причины повышенных и пониженных значений
Показания к исследованию крови методом ИФА
При помощи этого анализа можно оценивать эффективность лечения, проводить комплексное исследование перед трансплантологическими операциями, определять состояние иммунодефицита и антитела к более 600 видов аллергенов. Исследование крови методом ИФА использует в качестве дополнительного способа обнаружения онкологических клеток. Назначают анализ при необходимости обнаружения антител к микробам, которые провоцируют венерические патологии:
- трихомониаз;
- сифилис;
- токсоплазмоз;
- микоплазмоз;
- уреаплазмоз.
При глистных инвазиях в анализе ИФА будет отмечен рост количества иммуноглобулинов. Проводится исследования для подтверждения наличия у больного:
- вируса Эпштейна-Барра;
- герпетических инфекций;
- цитомегаловируса;
- группы вирусных гепатитов.

Опыт других людей
Иммунологический анализ (ИФА) – это высокоточный метод исследования, который позволяет определить наличие антител к различным инфекциям и другим веществам в организме. Результаты ИФА могут дать информацию о наличии или отсутствии определенных заболеваний, а также о состоянии иммунной системы. Методика проведения ИФА не требует сложной подготовки и обладает высокой чувствительностью и специфичностью. Люди, обратившиеся за проведением ИФА, отмечают его быстроту и точность результатов, что позволяет своевременно начать лечение или принять профилактические меры.
В паразитологии
Анализ ИФА используется в диагностике паразитарных патологий, показателем становится специфический иммуноглобулин IgE. Отмечается его рост в крови при заражении организма пациента паразитами. Иммуноглобулин Е становится маркером атопической реакции при аллергических процессах. Содержание в крови – незначительное. Локализуется, как правило, на слизистых оболочках, макрофагах, базофилах.
Основная функция белкового комплекса – защита слизистых оболочек организма. Также он участвует в иммунных реакциях, которые направлены на уничтожение паразитов. Отвечают за активизацию IgE макрофаги и эозинофилы. При сопоставлении с данными анализа этот факт помогает установить диагноз. Анализ ИФА используют для обнаружения:
- хронической, острой формы описторхоза;
- круглых гельминтов: остриц, аскарид;
- лямблий;
- трихинеллеза;
- амебиаза;
- форм лейшманиоза;
- содержания токсоплазм.
Анализ крови методом ИФА
Иммуноферментное исследование крови не единственный вариант для определения иммуноглобулинов. Иногда для этого исследования делают забор спинномозговой жидкости, ткани стекловидного тела, околоплодных вод. При использовании крови набирают ее из локтевой вены при помощи инъекционной иглы. Сдавать анализ необходимо натощак, перед ИФА не рекомендуется принимать медицинские препараты, которые могут повлиять на результат. Следует отказаться от алкоголя, курения, употребления наркотических веществ перед сдачей биоматериала. Варианты результатов теста:
- При отрицательных показателях иммуноглобулинов IgG, IgM, IgA, врачи говорят об отсутствии патологии или начальной стадии. Такой же результат (отрицательный) будет после полного выздоровления по прошествии длительного периода.
- Если IgG проявляется положительно, а IgM и IgA не обнаружены, это указывает на образование иммунитета после прививки или инфекционной болезни.
- При высоких титрах IgM и отрицательных IgA, IgG ставят диагноз острого инфекционного заболевания.
- При положительном показателе IgG, IgM, IgA врачи говорят об острой фазе рецидива уже имеющегося хронического недуга.
- При хронической инфекции, которая находится на стадии стихания (ремиссии), анализ ИФА показывает отрицательные титры IgM, а IgA и IgG будут положительными.
Преимущества и недостатки ИФА анализа
Основным отрицательным моментом этого исследования является вероятность получения ложноположительных или ложноотрицательных результатов. Причиной недостоверности становится прием медикаментов, технические недочеты лаборатории. Фальсифицировать анализ может процесс нарушения метаболизма в организме. Главными достоинствами анализа ИФА являются:
- точность, диагностическая специфичность;
- невысокая себестоимость анализа;
- скорость получения результатов;
- возможность динамического контроля стадии патологии, эффективности лечения;
- простота исследования;
- возможность выполнять массовые обследования очагов инфекции;
- безболезненность, безопасность для больного;
- применение при обработке информационных технологий.
Видео
Внимание!
Информация, представленная в статье, носит ознакомительный характер. Материалы статьи не призывают к самостоятельному лечению. Только квалифицированный врач может поставить диагноз и дать рекомендации по лечению, исходя из индивидуальных особенностей конкретного пациента.
Статья обновлена: 18.04.2018
Частые вопросы
Какие бывают методы ИФА?
Прямой неконкурентный ИФА Используется для определения антигена. … Непрямой неконкурентный ИФА Используется для определения антител. … «Сэндвич» Используется для определения антигена. … Прямой конкурентный ИФА Используется для определения антигена или антитела. … Непрямой (косвенный) конкурентный ИФА
Какие болезни показывает анализ ифа?
Гепатит В: HBsAg (кач.),Гепатит С: Anti-HCV сумм (кач.),ВИЧ-инфекция: Anti-HIV 1/2 (кач.),Диагностика сифилиса: РПГА (кач.),Диагностика сифилиса: РПГА (п/кол.),Диагностика сифилиса: Anti-Treponema pallidum IgM (кач.),Ещё
Что входит в иммуноферментный анализ?
Название «иммуноферментный анализ» включает 2 диагностических этапа процедуры: иммунный и ферментный. Иммунная реакция идет между готовыми образцами антител и предполагаемым антигеном в крови пациента с формированием иммунных комплексов.
Сколько делается анализ крови методом ИФА?
ИФА проводятся в лаборатории с венозной кровью и могут выявить антитела к ВИЧ и р24 антиген с 18–45 дня после инфицирования. В среднем, результаты анализа готовы на следующий день после забора крови. В настоящее время ИФА наиболее распространенный метод диагностики ВИЧ-инфекции.
Полезные советы
СОВЕТ №1
Понимание принципов работы ИФА анализа поможет вам лучше интерпретировать полученные результаты. Изучите основные этапы проведения данного исследования.
СОВЕТ №2
Обратитесь к специалисту, если у вас возникли вопросы по результатам ИФА анализа. Только квалифицированный врач сможет правильно проанализировать данные и дать рекомендации.